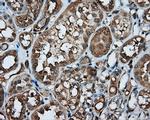
PPP5C Antibody in Immunohistochemistry (Paraffin) (IHC (P))

Search
OriGene
PPP5C Monoclonal Antibody (OTI4E1), TrueMAB™
{{$productOrderCtrl.translations['antibody.pdp.commerceCard.promotion.promotions']}}
{{$productOrderCtrl.translations['antibody.pdp.commerceCard.promotion.viewpromo']}}
{{$productOrderCtrl.translations['antibody.pdp.commerceCard.promotion.promocode']}}: {{promo.promoCode}} {{promo.promoTitle}} {{promo.promoDescription}}. {{$productOrderCtrl.translations['antibody.pdp.commerceCard.promotion.learnmore']}}
产品信息
CF500571
种属反应
宿主/亚型
分类
类型
克隆号
抗原
偶联物
形式
浓度
纯化类型
保存液
内含物
保存条件
运输条件
产品详细信息
For reconstitution, we recommend adding 100 µL distilled water to a final antibody concentration of about 1 mg/mL. To use this carrier-free antibody for conjugation experiments, we strongly recommend performing another round of desalting. (Zeba Spin Desalting Columns, 7KMWCO, 0.5 mL, Product # 89882)
靶标信息
This gene encodes a serine/threonine phosphatase which is a member of the protein phosphatase catalytic subunit family. Proteins in this family participate in pathways regulated by reversible phosphorylation at serine and threonine residues; many of these pathways are involved in the regulation of cell growth and differentiation. The product of this gene has been shown to participate in signaling pathways in response to hormones or cellular stress, and elevated levels of this protein may be associated with breast cancer development. Alternative splicing results in multiple transcript variants.
仅用于科研。不用于诊断过程。未经明确授权不得转售。
篇参考文献 (0)
生物信息学
蛋白别名: FLJ36922; FLJ55954; OTTHUMP00000165834; PP-T; PP5; protein phosphatase 5, catalytic subunit; Protein phosphatase T; Serine/threonine-protein phosphatase 5
基因别名: PP5; PPP5; PPP5C; PPT
UniProt ID: (Human) P53041
Entrez Gene ID: (Human) 5536